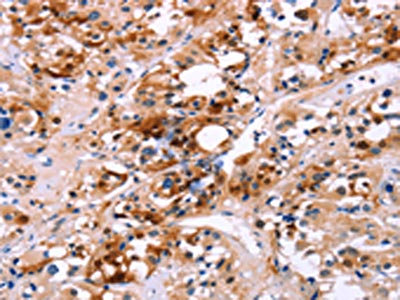

CALB1 Antibody
-
中文名稱:CALB1兔多克隆抗體
-
貨號(hào):CSB-PA221830
-
規(guī)格:¥1100
-
圖片:
-
The image on the left is immunohistochemistry of paraffin-embedded Human thyroid cancer tissue using CSB-PA221830(CALB1 Antibody) at dilution 1/60, on the right is treated with fusion protein. (Original magnification: ×200)
-
Gel: 8%SDS-PAGE, Lysate: 40 μg, Lane 1-3: Mouse brain tissue, Mouse kidney tissue, human fetal brain tissue, Primary antibody: CSB-PA221830(CALB1 Antibody) at dilution 1/750, Secondary antibody: Goat anti rabbit IgG at 1/8000 dilution, Exposure time: 1 second
-
-
其他:
產(chǎn)品詳情
-
Uniprot No.:
-
基因名:
-
別名:avian-type antibody; CAB27 antibody; CALB 1 antibody; CALB antibody; CALB1 antibody; CALB1_HUMAN antibody; Calbindin 1 28kDa antibody; Calbindin antibody; Calbindin D28 antibody; D 28K antibody; D-28K antibody; D28K antibody; OTTHUMP00000166027 antibody; OTTHUMP00000225441 antibody; RTVL H protein antibody; Vitamin D dependent calcium binding protein antibody; Vitamin D dependent calcium binding protein avian type antibody; Vitamin D-dependent calcium-binding protein antibody
-
宿主:Rabbit
-
反應(yīng)種屬:Human,Mouse,Rat
-
免疫原:Fusion protein of Human CALB1
-
免疫原種屬:Homo sapiens (Human)
-
標(biāo)記方式:Non-conjugated
-
抗體亞型:IgG
-
純化方式:Antigen affinity purification
-
濃度:It differs from different batches. Please contact us to confirm it.
-
保存緩沖液:-20°C, pH7.4 PBS, 0.05% NaN3, 40% Glycerol
-
產(chǎn)品提供形式:Liquid
-
應(yīng)用范圍:ELISA,WB,IHC
-
推薦稀釋比:
Application Recommended Dilution ELISA 1:2000-1:5000 WB 1:500-1:2000 IHC 1:50-1:200 -
Protocols:
-
儲(chǔ)存條件:Upon receipt, store at -20°C or -80°C. Avoid repeated freeze.
-
貨期:Basically, we can dispatch the products out in 1-3 working days after receiving your orders. Delivery time maybe differs from different purchasing way or location, please kindly consult your local distributors for specific delivery time.
-
用途:For Research Use Only. Not for use in diagnostic or therapeutic procedures.
相關(guān)產(chǎn)品
靶點(diǎn)詳情
-
功能:Buffers cytosolic calcium. May stimulate a membrane Ca(2+)-ATPase and a 3',5'-cyclic nucleotide phosphodiesterase.
-
基因功能參考文獻(xiàn):
- CSF calbindin concentration is a sensitive biomarker of NPC1 disease PMID: 27307499
- We identified a significant association between the A allele of rs1805874 and the risk of Parkinson's disease (OR 1.257, 95% CI 1.036-1.524, p = 0.020). Our findings suggest that the A allele of rs1805874 is associated with risk of Parkinson's disease among the Han Chinese. Our results, combined with previous studies, suggest that rs1805874 is associated with Parkinson's disease in East Asians, but not Caucasians. PMID: 27611799
- Age-related loss of CB appears to coincide with tangle formation in the BFCN and is associated with the full range of tau pathology, including late appearing epitopes. PMID: 26417681
- Increased number of calbindin neurons and fiber labeling both in focal cortical dysplasia (FCD) and non-FCD specimens compared with postmortem controls may be associated with ongoing seizure activity. PMID: 26081613
- expressed by different neuron types, both inhibitory (GABAergic) and excitatory (glutamatergic), involved in both intrinsic and extrinsic circuits of the human cerebellar cortex PMID: 24719368
- The calbindin-D 28k was decreased in the putamen, the dorsal tier of the substantia nigra along the lower border of the red nucleus, and in the cerebellar cortex in multiple system atrophy. PMID: 23715974
- Significantly reduced hippocampal calbindin D28K levels are found in all patients with mitochondrial encephalomyopathy, lactic acidosis and stroke-like syndrome (MELAS). PMID: 22483853
- Data show calbindin (CB)- and tyrosine hydroxylase (TH)-cells were distributed in the three striatal territories, and the density of calretinin (CR) and parvalbumin (PV) interneurons were more abundant in the associative and sensorimotor striatum. PMID: 22272358
- Dynamics of Ca2+ ions within the solvation shell of calbindin D9k. PMID: 21364983
- upregulated in endometriosis tissues PMID: 20452033
- cultured syncytiotrophoblast cells express calbindin-D9k and calbindin-D28k genes, which are stimulated by calcitriol PMID: 20214988
- Our study shows there is no association between rs1805874 and risk for Parkinson's disease (PD) in four Caucasian populations. This suggests the effect of calbindin on PD risk displays population specificity. PMID: 19674066
- calbindin may play a role in development of Purkinje cells located in heterotopias and cerebellar dysgenesias PMID: 20054781
- S-nitrosation of Ca(2+)-loaded and Ca(2+)-free recombinant calbindin D(28K) from human brain. PMID: 11994015
- binds to myo-inositol-1(or 4)-monophosphatase (IMPase) and increases the phosphatase activity PMID: 12176979
- calbindin 1, 28kDa may play a role in Ca2+ transport or cell development in human trophoblast possibly trough Ca2+ buffering PMID: 12606474
- The biological function of calbindin D28k appears to be tied to the redox state of its five cysteine residues. PMID: 15641794
- Post-translational modifications of human calbindin. PMID: 15741335
- Our findings indicate that the expression of parvalbumin or calbindin-D(28k) by subpopulations of dysplastic neurons in cortical tubers is aberrant and denotes dysfunctional inhibitory circuits inept for excitoprotection. PMID: 17156698
- aggregates of mutant ataxin-l may recruit calbindin-D28k via tissue transglutaminase 2 mediated covalent crosslinking PMID: 17442486
- recombinant human calbindin-D28k was crystallized at 291 K using PEG 3350 as precipitant and a 2.4 A resolution X-ray data set was collected from a single flash-cooled crystal PMID: 18259068
- calbindin D(28k) binds Zn2+ to 3 rather strong sites with dissociation constants in low micromolar range. Zn2+-bound state is structurally distinct from Ca2+-bound state, with negative allosteric interaction between Zn- & Ca-binding events. PMID: 18359862
- CALB1 is associated with Parkinson's disease independently of alpha-synuclein. PMID: 18568448
- No significant differences in cerebellar Purkinje cells in levels of CALB in autism or in the normal cerebellum. PMID: 18587625
顯示更多
收起更多
-
蛋白家族:Calbindin family
-
數(shù)據(jù)庫鏈接:
Most popular with customers
-
-
YWHAB Recombinant Monoclonal Antibody
Applications: ELISA, WB, IHC, IF, FC
Species Reactivity: Human, Mouse, Rat
-
Phospho-YAP1 (S127) Recombinant Monoclonal Antibody
Applications: ELISA, WB, IHC
Species Reactivity: Human
-
-
-
-
-